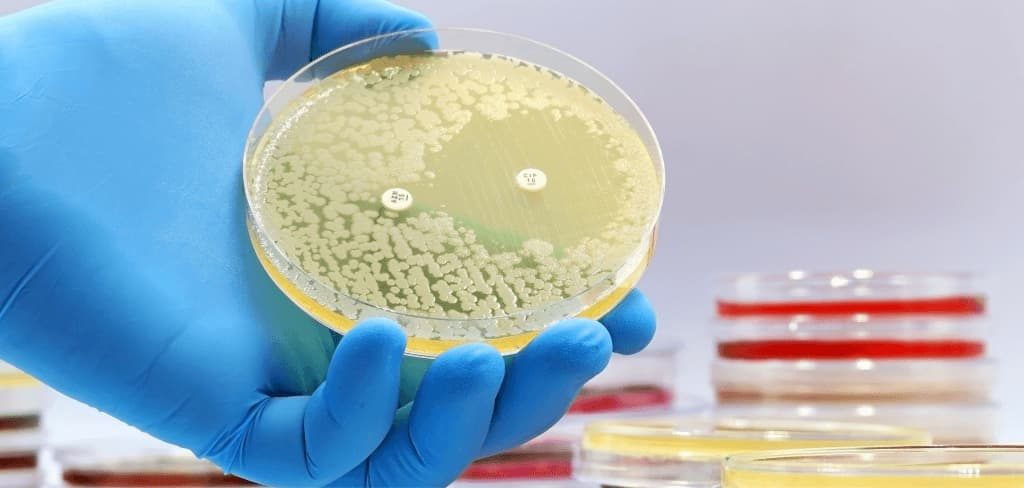
resistencia-antibioticos-placa-petri Caja de Petri con bacterias resistentes a antibióticos en laboratorio

Resistencia bacteriana: Riesgos y prevención
Última actualización: 11 de junio de 2025.
4 min de lectura
Tabla de contenido
La resistencia a los antibióticos es un problema grave que preocupa a médicos y científicos en México y el mundo. En este artículo, te explicamos qué la causa, por qué nos afecta a todos y, sobre todo, qué podemos hacer para combatirla.
💡 ¿Sabías que el 50% de los antibióticos se usan incorrectamente? Conoce cómo saber si necesitas tomar antibióticos antes de automedicarte.
¿Qué es la resistencia bacteriana?
Cuando los antibióticos ya no le hacen efecto a las bacterias, estamos hablando de resistencia bacteriana. Esto pasa porque los microbios se adaptan y se vuelven más fuertes, haciendo que los tratamientos ya no sirvan como antes.
Definición a fondo
La resistencia bacteriana es cuando las bacterias cambian y logran aguantar los efectos de los medicamentos que antes las mataban. Esto es un problema serio porque infecciones que antes se curaban fácil, ahora pueden volverse peligrosas e incluso mortales.
¿Por qué las bacterias se hacen resistentes?
Las bacterias no son ingenuas: si se exponen mucho a los antibióticos pero no se eliminan por completo, las que sobreviven aprenden a defenderse. También pasa cuando la gente usa mal los medicamentos, como no terminar el tratamiento o automedicarse.
💊 El uso excesivo de antibióticos en animales (OMS) también contribuye al problema.
Peligros de la resistencia bacteriana en México
Esto no es un tema menor: cada año, miles de mexicanos se infectan con bacterias que ya no responden a los antibióticos comunes, y muchas personas pueden perder la vida por esta causa.
Casos que preocupan
Por ejemplo, infecciones de orina, neumonías o heridas simples se están volviendo más difíciles de tratar porque los antibióticos ya no son efectivos. En hospitales, bacterias como Klebsiella o E. coli están mostrando altos niveles de resistencia.
¿Por qué nos debe importar?
Si esto sigue así, cirugías rutinarias, partos o quimioterapias podrían volverse de alto riesgo, ya que sin antibióticos eficaces, cualquier infección podría ser mortal.
👉 ¿Sabías que un chequeo general anual puede prevenir complicaciones?
Causas de la resistencia (y en qué estamos fallando)
Antibióticos usados sin control
En México, mucha gente los toma sin receta (para gripas o diarreas, aunque no sirvan para eso) o los compra sin supervisión médica. Incluso en la ganadería, se usan en exceso.
Tratamientos a medias
Suspender los antibióticos cuando "ya te sientes mejor" (pero antes de terminar el ciclo) es un error grave que favorece la resistencia.
¿Sabías que algunas personas son genéticamente más propensas a sufrir efectos adversos con ciertos antibióticos?🧬 Nuestro perfil genético de tolerancia a medicamentos analiza cómo tu cuerpo metaboliza fármacos comunes, ayudando a tu médico a recetarte el tratamiento más seguro y efectivo para ti.
Cómo poner de nuestra parte para frenar el problema
Lo que puedes hacer tú
Acciones del sector salud en México
Hay regulaciones más estrictas para evitar la venta sin receta, y se promueve el uso responsable en hospitales y consultorios.
Preguntas frecuentes sobre las resistencias
¿Se puede revertir la resistencia?
No de inmediato, pero si reducimos el mal uso de antibióticos, las bacterias pueden perder resistencia con el tiempo.
¿Qué enfermedades se están complicando?
Infecciones como neumonía, gonorrea y sepsis son cada vez más difíciles de tratar por este problema.
Conclusión: Frenar la resistencia bacteriana es tarea de todos
La resistencia bacteriana no es un problema del futuro, ya está aquí y en México nos está pegando fuerte. Si seguimos usando los antibióticos a lo loco, pronto podríamos enfrentarnos a infecciones que antes se curaban con una pastilla y ahora requerirán hospitalizaciones largas—o incluso no tendrán cura.
Pero no todo está perdido: la solución está en nuestras manos. Desde no automedicarnos hasta seguir al pie de la letra las indicaciones del médico, cada acción cuenta. Las autoridades, por su parte, deben seguir regulando la venta de antibióticos y promoviendo campañas de concientización.
¿La buena noticia? Si actuamos ahora, podemos evitar que esto se vuelva una crisis peor. El momento de cambiar es hoy: por tu salud, la de tu familia y la de todos los mexicanos.
¿Ya compartiste esta información? Mucha gente todavía no sabe del peligro de la resistencia bacteriana. Ayuda a correr la voz compartiendo este artículo o hablando del tema con tus conocidos. ¡Juntos le podemos ganar esta batalla a las bacterias!
¿Necesitas un análisis clínico? Consulta nuestros servicios de laboratorio con resultados confiables y rápidos.